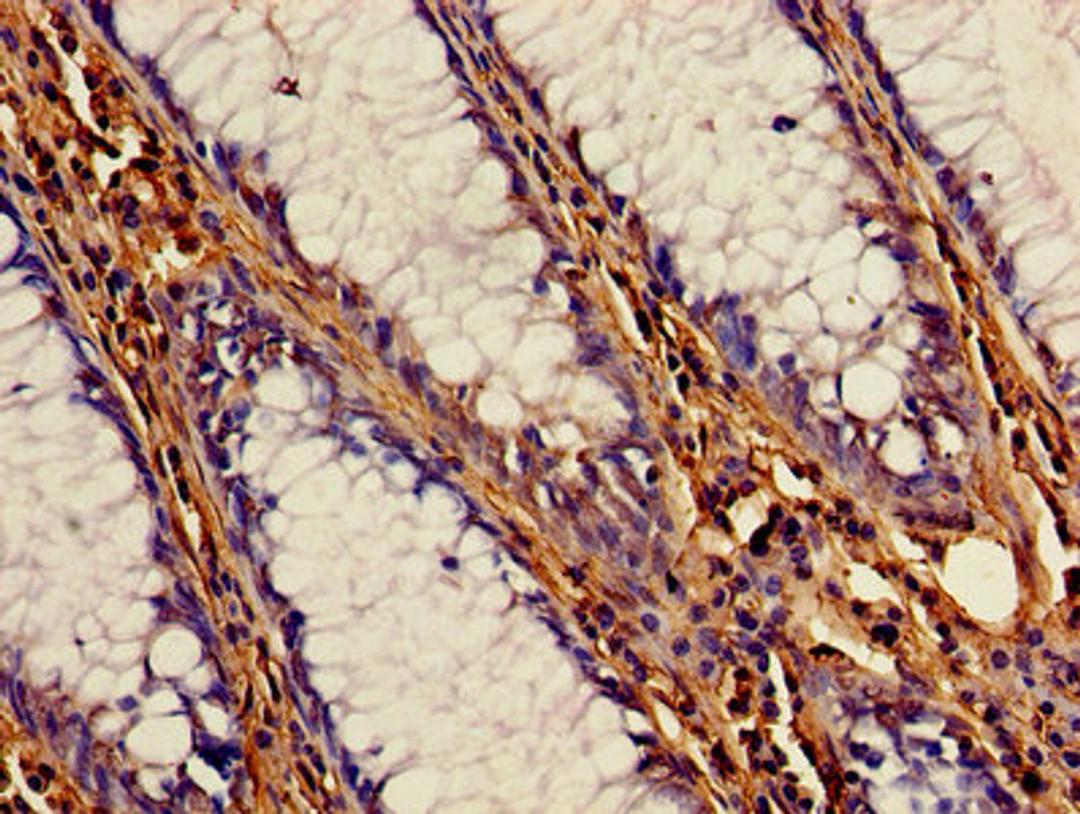
Immunohistochemistry of paraffin-embedded human colon cancer using CSB-PA00224A0Rb at dilution of 1:100

Product & ReviewsAntibodies
CSTB Antibody
Product Details
- Cat. No.
- CSB-PA00224A0Rb
- Type
- Primary Antibody
- Clonality
- Polyclonal
- Host
- Rabbit
Reviews
Applications
- ELISA (ELISA)
- Western Blotting (WB)
- Immunohistochemistry (IHC)
- Immunofluorescence (IF)
- Immunoprecipitation (IP)